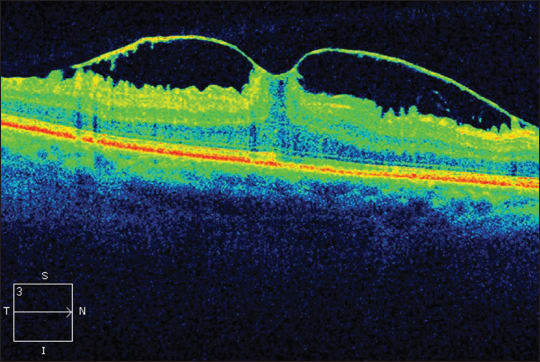
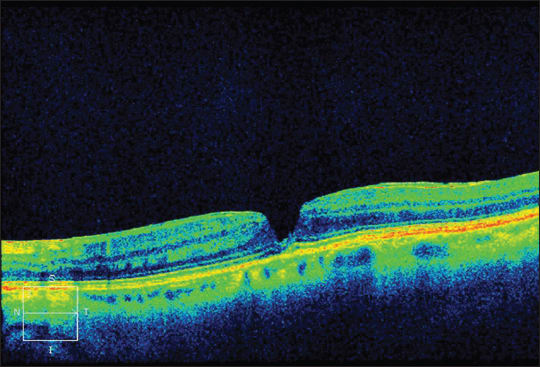

Differential Diagnosis of Macular Holes and Pseudoholes
The advent of OCT has allowed far more accurate diagnoses
Shao-Onn Yong, BSc (Hons), MBBS, MMED, FRCSE • Wai-Ching Lam, MD, FRCSC
Vitreomacular interface pathology is a term used to describe a group of conditions involving the macula, consisting of full-thickness macular holes (FTMH), lamellar macular holes (LMH), macular pseudoholes (MPH), vitreomacular traction (VMT) and myopic macular schisis. At first glance, these conditions seem to be discrete entities with distinctive features and definitions to match. As described by Gass1 and Altaweel and Ip,2 a FTMH (with the exception of stage 1A and 1B holes) consists of a defect involving all layers of the retina up to the retinal pigment epithelium.
The term LMH was first coined by Gass3 in 1975 to describe a macular lesion resulting from cystoid macular edema following cataract surgery. By definition, an LMH has residual outer retinal tissue covering the foveal RPE, and the term has since been used by Gass4 and Takahashi and Kishi5 to describe an abortive FTMH. An MPH on the other hand, has been defined as a macular lesion that has the appearance of a FTMH but that does not have a loss of foveal tissue, and this term was attributed by Allen and Gass6 to the centripetal contraction of a surrounding epiretinal membrane.
However, it quickly becomes apparent that there is considerable overlap between the conditions. For starters, the biomicroscopic appearance of these three conditions is similar: a single, round, usually well-circumscribed reddish lesion located over the fovea. Furthermore, although FTMH is usually distinguishable from LMH and PMH by virtue of the associated significant central visual loss and positive Watzke-Allen and laser aiming beam tests, clinical differentiation between LMH and MPH may be complicated by similarities between the two conditions. For instance, visual acuities may be normal, or mildly impaired, at approximately 20/40. Amsler grid, Watzke-Allen and laser aiming beam tests are often negative or equivocal. Additionally, ERMs, which were initially thought to be strongly associated with MPH, have also reported to be commonplace in patients with LMH.7,8
DIFFERENTIATING VITREORETINAL INTERFACE PATHOLOGY
While earlier reports on macular interface pathology were based on clinical biomicroscopic examination, much has occurred in the intervening decades to improve our understanding of the pathological processes occurring at the vitreomacular interface. The advent of optical coherence tomography, in particular, has enabled clinicians to visualize the vitreomacular interface, as well as the macular retinal cross-section, with increasing detail.
Earlier iterations of time-domain OCTs (eg, commercially available Stratus OCT, Carl Zeiss Meditec) relied on correlating the time echo of light backscattering off retinal structures to provide images with up to 8 µm axial and 20 µm transverse resolution in tissue, consisting of 1,024 axial pixels and 512 transverse pixels (ie, a total of 524,288 pixels).
In a retrospective study of 71 eyes from seven patients diagnosed with MPH or LMH on OCT (30 µm axial resolution), Haouchine et al.7 reported that the characteristic macular profile of MPH (steepened foveal pit combined with thickened foveal edges and a small foveal pit diameter) was observed in 40 cases (56%). On biomicroscopy, 49 of the 71 eyes (69%) were diagnosed with MPH, based on the presence of a well-delineated round or oval image of the macula and the presence of a definite ERM with retinal folds.
There was, however, a far greater discrepancy between the biomicroscopic diagnosis of LMH (combined with a pseudo-operculum) in 10 eyes (14%) and the OCT diagnosis of LMH in 29 eyes (41%). The OCT profile corresponding to LMH was characterized by a thin, irregular foveal floor, split foveal edges and near-normal perifoveal retinal thickness.
Mean central foveal thickness was normal or slightly increased (167 ± 42 µm) in MPH, whereas it was reduced in LMH (72 ± 19 µm). Eighteen of 29 LMH eyes (62%) were found to have concurrent ERM.
THE UTILITY OF INCREASED RESOLUTION
Witkin et al.8 employed a prototype femtosecond titanium-sapphire laser ultra-high resolution (UHR) OCT system to investigate 1,205 eyes of 664 patients. UHR OCT provided images of 3 µm axial resolution and 15 to 20 µm transverse resolution in tissue, consisting of 3,000 axial and 6,000 transverse pixels (total 1.8 million pixels).
Nineteen eyes of 18 patients were retrospectively diagnosed with LMH based on UHR OCT criteria similar to those described above, namely (1) an irregular foveal contour, (2) a break in the inner fovea, (3) separation of the inner from the outer foveal retinal layers, leading to an intraretinal split, and (4) absence of a full-thickness foveal defect with intact photoreceptors posterior to the area of foveal dehiscence (Figure 1).

Figure 1. SD-OCT demonstrating lamellar hole features described by Witkin et al.8 The OCT demonstrates an irregular foveal contour, a break in the inner fovea, an intraretinal split with bridging columns and the absence of a full thickness foveal defect. An ERM is also present.
Stratus OCT, which was also performed on the study eyes, was also able to demonstrate the four OCT criteria for LMH diagnosis in all 19 eyes. However, UHR OCT revealed additional structural details not visible on the Stratus OCT. For example, UHR OCT demonstrated that the intraretinal split occurred either between the high backscattering OPL and the low backscattering ONL or within the OPL in all 19 eyes. Additional findings seen on UHR OCT included ERMs, vitreomacular traction, and a visibly detached posterior hyaloid above the macula.
On initial clinical examination, only seven of 19 (37%) eyes were initially diagnosed with an LMH. Twelve eyes (63%) were reported to have an ERM clinically, whereas UHR OCT detected ERMs in 17 of 19 eyes (89%). These findings were consistent with Haouchine et al. in emphasizing the utility of OCT in diagnosis of LMH. The higher incidence of ERM in this study was attributed to increased resolution of the UHR OCT, which enhanced the ability to detect ERMs.
PATHOGENESIS/MECHANISMS OF LMH FORMATION
Tangential Traction vs Anteroposterior Traction
It has been postulated that the various lesions that manifest as macular interface pathology are the result of tractional forces working on the foveal and perifoveal retina. These forces are classically divided into anteroposterior vitreoretinal traction forces, as well as tangential traction forces. These latter tangential forces may result from ERMs or eccentric perifoveal vitreoretinal attachment and partial posterior vitreous detachment.
While a broad, posterior PVD may be detected clinically by noting the presence of a Weiss ring, the partial PVDs (vitreofoveal adherence with adjacent vitreoretinal separation; see Figure 2) implicated in hole formation are difficult to detect clinically and are more readily seen on OCT.
Figure 2. SD-OCT demonstrating partial PVD with vitreo-foveal traction and concurrent ERM.
Similarly, OCT has been shown to be far more sensitive than clinical examination in detecting ERMs (Figure 3).

Figure 3. Subtle ERM (arrowheads) demonstrated on SD-OCT, with reduction of foveal depression (arrow).
Foveal Cystic Changes as a Precursor to Hole Formation
Haouchine et al.9 suggested that the tractional forces on the fovea resulted in the formation of intraretinal spaces (termed “pseudocysts”) or foveal detachment, and that these were the first steps in LMH or FTMH formation.
A retrospective Stratus OCT study reported by Yeh et al.10 further classified eyes with vitreofoveal traction (termed “impending holes”), according to the presence of foveal detachment with an intact inner retinal lining (Type A; see Figure 4), or with single or multiple inner retinal cysts with intact inner and outer retinal linings (Type B; see Figure 5). Without surgical intervention to relieve vitreofoveal traction, eyes with foveal detachments (Type A) all went on to develop FTMH within six months, while none of the cases with inner retinal cysts only (Type B) developed foveal detachment or advanced to FTMH (mean 11.4 ±3.5 months of follow-up). Five of 15 eyes (33%) with Type B impending holes did, however, evolve to become LMHs at an average of 7.6 ±3.1 months.

Figure 4. SD-OCT of foveal detachment. This has variously been classified as stage 1b macular hole by Altaweel and Ip2 and also type 1A impending hole by Yeh et al.10 and thought to be the precursor of FTMH.

Figure 5. Stratus OCT of vitreofoveal traction associated with inner retinal pseudocyst formation (type 1B impending hole), which is suggested by Yeh et al.10 to be a precursor of LMH.
Role of ERM in LMH Formation
Witkin et al.8 noted that only 10 of 19 eyes (53%) with LMH had a PVD (which would have been indicative of an abortive FTMH process) on examination or on OCT. They further noted that the remaining nine eyes without PVDs all had ERMs, along with eight of 10 of the eyes with PVDs. ERM contraction was therefore postulated to play a role in LMH formation in many patients, similar to the formation of a MPH.
Similarly, Haouchine et al.7 reported pseudo-opercula (suggestive of an aborted macular hole) in only 24% of patients.
Michalewski et al.11 reported a spectral-domain OCT study of two patients with MPH who went on to develop LMH within six months. Neither patient was diabetic or had a history of macular edema. The role of vitreoretinal traction was excluded, as PVD was present at the initial examination. This finding suggests that MPH may not simply be a separate, stable, clinical entity, as previously thought, but may also be capable of evolving to LMH, and perhaps also to FTMH.
The Utility of Increased Scan Density
Spectral-domain OCT, which has come into widespread use in the past five years or so, enables imaging speeds of >25,000 axial scans per second, or ~50 times faster than time-domain detection.12 The scanning protocol in time-domain OCT (including UHR OCT) relies on six linear macular scans arranged in a star pattern centered on the fovea, whereas the superior image-acquisition speed of SD-OCT devices allows for densely spaced raster scans to be performed over a large area of retina in a short time. This process allows three-dimensional reconstruction of scan data, which has the dual advantages of allowing mapping to retinal landmarks and, hence, longitudinal tracking of retinal pathology, as well as reducing the risk of focal lesions (eg, small pseudocysts or focal dehiscence of the inner or outer retina) being missed.
The fast imaging speed also affords a significant improvement over time-domain OCT in sensitivity (3-5 µm axial resolution, comparable to UHR OCT) by reducing the occurrence of motion artifacts (Figure 6).

Figure 6. Stratus OCT demonstrating foveal detachment. The presence of a FTMH cannot be ruled out because of the presence of artifact that may mask the presence of a combined inner and outer retinal break (arrowhead).
CONCLUSION
Optical coherence tomography has revolutionized our ability to visualize and examine the vitreomacular interface. This evolution has not only allowed clinicians to differentiate between the various pathologies more accurately, but it has also led to a better appreciation of the processes that are involved in creating these conditions. In turn, there has been a change in the paradigm of viewing the pathologies as separate entities toward recognition that they are all part of a spectrum, sharing the same pathological processes (Figures 7, 8, and 9).

Figure 7. Flowchart of evolution of macular interface pathology and reported mechanisms of pathogenesis.
Figure 8. SD-OCT demonstrating MPH (ERM and steepened foveal contour), but with reduced foveal retinal thickness more commonly associated with LMH.

Figure 9. SD-OCT of FTMH with LMH features of intraretinal split and ERM.
Further improvements in OCT technology, such as increased resolution and real-time (four-dimensional) OCT, will no doubt shed more light on these conditions and perhaps aid clinicians in management decisions and prognostication. RP
REFERENCES
1. Gass JDM. Reappraisal of biomicroscopic classification of stages of development of a macular hole. Am J Ophthalmol. 1995;119:752-759.
2. Altaweel M, Ip M. Macular hole: improved understanding of pathogenesis, staging, and management based on optical coherence tomography. Semin Ophthalmol. 2003;18:58-66.
3. Gass JD. Lamellar macular hole: a complication of cystoid macular edema after cataract extraction: a clinicopathologic case report. Trans Am Ophthalmol Soc. 1975;73:231-250.
4. Gass JDM. Vitreofoveal separation and lamellar hole formation. In: Gass JDM, ed. Stereoscopic Atlas of Macular Diseases: Diagnosis and Treatment. 4th ed. St. Louis, MO; Mosby; 1997:926-927.
5. Takahashi H, Kishi S. Tomographic features of a lamellar macular hole formation and a lamellar hole that progressed to a full-thickness macular hole. Am J Ophthalmol. 2000;130:677-679.
6. Allen AW Jr, Gass JD. Contraction of a perifoveal epiretinal membrane simulating a macular hole. Am J Ophthalmol. 1976;82:684-691.
7. Haouchine B, Massin P, Tadayoni R, Erginay A, Gaudric A. Diagnosis of macular pseudoholes and lamellar macular holes by optical coherence tomography. Am J Ophthalmol. 2004;138:732-739.
8. Witkin AJ, Ko TH, Fujimoto JG, et al. Redefining lamellar holes and the vitreo-macular interface: an ultrahigh-resolution optical coherence tomography study. Ophthalmology. 2006;113:388-397.
9. Haouchine B, Massin P, Gaudric A. Foveal pseudocyst as the first step in macular hole formation: a prospective study by optical coherence tomography. Ophthalmology. 2001;108:15-22.
10. Yeh PT, Chen TC, Yang CH, et al. Formation of idiopathic macular hole - reappraisal. Graefes Arch Clin Exp Ophthalmol. 2010;248:793-798.
11. Michalewski J, Michalewska Z, Dzie gielewski K, Nawrocki J. Evolution from macular pseudohole to lamellar macular hole - spectral domain OCT study. Graefes Arch Clin Exp Ophthalmol. 2011;249:175-178.
12. Nassif NA, Cense B, Park BH, et al. In vivo high-resolution video-rate spectral-domain optical coherence tomography of the human retina and optic nerve. Opt Express. 2004;12:367-376.
| Shao-Onn Yong, BSc (Hons), MBBS, MMed, FRCSE, is on the faculties of the Department of Ophthalmology & Vision Sciences at the University of Toronto, the Department of Ophthalmology at Tan Tock Seng Hospital in Singapore, and the Department of Ophthalmology at Yong Loo Lin School of Medicine at the National University of Singapore. Wai-Ching Lam, MD, FRCSC, is on the faculties of the Department of Ophthalmology & Vision Sciences at U. Toronto and the Department of Ophthalmology at Toronto Western Hospital. Dr. Yong reports no financial interest in any products mentioned in this article. Dr. Lam reports financial interest in Alcon, Allergan, Novartis, and Pfizer. Dr. Lam can be reached via e-mail at waiching.lam@utoronto.ca. |








